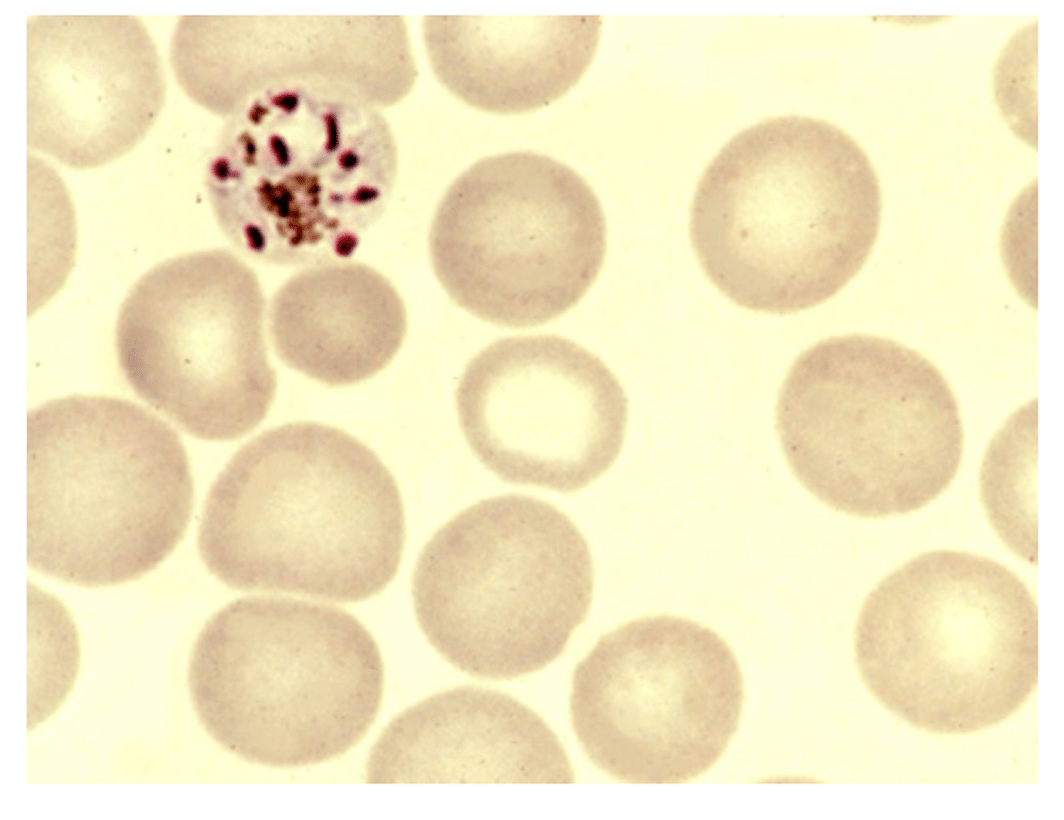

2. Which of the following conditions is caused by Trypanosoma cruzi?
a. Malaria
b. Chagas’ Disease
c. Tapeworms
d. Sleeping Sickness
Chagas’ Disease
(T. cruzi is trasmitted via the bite of a reduviid bug and causes Chagas’ disease. It presents with an erythematous nodule at the site of infection typically the face)
9. Enterobius vermicularis (pinworm) is classified as which of the following?
a. Nematode
b. Trematodes
c. Filaria
d. Cestode
Nematode
(This is correct as roundworms are long, round or cylindrical in shape, and often can resemble earthworms. Enterobius vermicularis is a commonly isolated intestinal helminth)
17. Which of the following amoeba cysts measures approximately 25 um?
a. Entamoeba hartmanni
b. Entamoeba histolytica
c. Entamoeba coli
d. Balantidium coli
Entamoeba coli
(This is correct as Entamoeba coli measures between 10-35 um and size is an important parasite-identifying feature)
12. The microorganism in the photograph was detected in muscle tissue. The most likely identification is:


a. Trichinella spiralis encysted larva
b. Strongyloides stercoralis filariform larva
c. Hookworm rhabditiform larva
d. Taenia solium cyst
Trichinella spiralis encysted larva
(Trichinella spiralis is the only nematode known to encyst in human muscle tissue and will coil up appearing as a snail)
18. What is this suspicious form seen in a stool sample that measures 10 um in diameter?

a. Iodamoeba butschlii trophozoite
b. Entamoeba histolytica trophozoite
c. Entamoeba coli trophozoite
d. An artifact
An artifact
(The suspicious form is an artifact as it does not contain any typical amebic nuclear structures commonly seen and cytoplasmic material in not present)
1. Which malarial species schizont that typically contains 6 to 12 merozoites with a central brown/green pigmented mass and sometimes forms rosette shapes is found inside red blood cells?
a. Plasmodium vivax schizont
b. Plasmodium ovale schizont
c. Plasmodium malariae schizont
d. Plasmodium falciparum schizont
Plasmodium malariae schizont
(This is correct as Plasmodium malariae are the only ones that typically contain 6-12 merozoites with large nuclei clustered around a mass or dark-brown/green pigment with the occasional presence of rosette forms)
3. The morphologic structures found in select tapeworms that are typically responsible for attaching to the human intestinal wall are called:
a. Hooklets
b. Polar plugs
c. Operculums
d. Polar thickenings
Hooklets
(Hooklets are structures attached to the rostellum of tapeworms (Cestodes). These hooklets are used to aid in the attachment of the worm to the host's intestinal lining. An example includes Taneia solium)
5. Spine-like pseudopods are characteristic for the trophozoite for which amoeba?
a. Entamoeba gingivalis
b. Acanthamoeba species
c. Naegleria fowleri
d. Cytosiospora belli
Acanthamoeba species
(Acanthamoeba species characteristically exhibit trophozoites that measure between 10-45 um with spine-like pseudopods. This species of amoeba are most often implicated in granulomatous amebic encephalitis, which is especially pathogenic in patients with impaired cellular immunity)
4. What is the correct classification for image C?

a. Ameoba
b. Hemoflagellate
c. Flagellate
d. Ciliate
Ciliate
(This is the correct answer because the image represents a Balantidium coli trophozoite. The anterior end of a B. coli trophozoite is pointed and has a cytostome or mouth opening)
19. This suspicious form measuring 120 um by 63 um was recovered from a stool specimen. What is the most likely identification?

a. Ascaris lumbricoides
b. Schistosoma japonicum
c. Schistosoma mansoni
d. Fecal contamination
Schistosoma mansoni
(Schistosoma mansoni is the organism present in the image and the most prominent identifying feature of these eggs is the presence of an obvious lateral spine. Humans are infected by direct penetration from the cercariae which enters the circulation, travels to the veins of the large colon where eggs are formed and passed into feces. This condition is often called “swimmer’s itch” )
7. The trophozoites of Babesia morphologically resemble which one of the following parasites?
a. Pneumocystisi jiroveci (carinii) trophozoites
b. Plasmodium falciparum rings
c. Leishmania donovani amastigotes
d. Trypanosoma cruzi trypomastigotes
Plasmodium falciparum rings
(The trophozoites of Babesia can mimic the rings of Plasmodium falciparum as they are both found intracellular to erythrocytes. Though Babesia trophozoites are smaller in size and more pleomorphic than the rings of Plasmodium falciparum)
11. Trichuris trichiura belongs to which helminth group?
a. Filariae
b. Trematodes
c. Nematodes
d. Cestodes
Nematodes
(This is correct because nematodes are elongated, cylindrical worms with a well-developed digestive tract and reproductive system like this intestinal nematode Trichuris trichiura)
14. Small proton cysts are found in a wet mount of sediment from ethyl-acetate concentrated material. Each cyst has 4 nuclei that do not have peripheral chromatin, and each nucleus has a lard karyosome, which appears as a refractive dot. These oval cysts are most likely:
a. Endolimax nana
b. Chilomastix mesnili
c. Entamoeba histolytica
d. Entamoeba hartmanni
Endolimax nana
(Endolimax nana cysts can be found to be 6-8 um in size, contain no chromatin and 4 nuclei)
16. This image represents parasites belonging to which of the following groups?

a. Blood Nematodes
b. Blood Hemoflagellate
c. Blood Sporozoite
d. Blood Protozoa
Blood Nematodes
(This is correct because the blood nematodes include parasites Wuchereria bancrofti, Brugia malayi, Loa loa, Onchocerca volvulus and Mansonella species)
10. This trophozoite measuring 120 um was observed in a stool specimen from an immune-compromised patient with low-grade diarrhea. Select the presumptive identification.

a. Entamoeba coli
b. Balantidium coli
c. Giardia intestinalis
d. Echinococcus granulosus
Balantidium coli
(This is correct as the size of the trophozoite is distinctive of Balantidium coli. The cell membrane is covered throughout the circumference with short cilia and kidney shaped macronucleus)
15. Not all strains of Entamoeba histolytica are pathogenic, and recent molecular studies indicated that there is a non-pathogenic variant of Entamoeba histolytica. What is the non-pathogenic variant?
a. Entamoeba hartmanni
b. Entamoeba moshkovskii
c. Entamoeba dispar
d. Entamoeba coli
Entamoeba dispar
(there are several DNA sequencing assays available to separate the non-pathogenic variant of Entamoeba dispar from E. histolytica)
8. As one of the morphological families of parasites, a feature that characterizes various Nematode species is:
a. Disease cannot be transmitted via a fecal to oral route
b. They are hermaphroditic
c. Addition of proglottids is the method by which they mature
d. Filariform larvae may serve as an infective form for humans
Filariform larvae may serve as an infective form for humans
(As with Strongyloides stercoralis, infections are acquired by skin penetration with filariform larvae)
6. Naegleria fowleri is associated with which one of the following diseases?
a. Amebic meningoencephalitis
b. Amebic encephalitis
c. Traveler's diarrhea
d. Non-pathogen
Amebic meningoencephalitis
(Naegleria fowleri trophozoites are found in water or moist soil where they are inhaled by an individual. The trophozoites then penetrate the nasal mucosa and migrate via the olfactory nerve to the brain)
13. Illustrated in the upper photograph is an adult fluke that is most commonly found in the distant bile ducts of the liver with human infection. The fluke is relatively small averaging 12-20 mm. The lower image is a close-in view of this fluke to better illustrate its internal structures. Symptoms may be minimal but liver enlargement and jaundice can be present in heavy infections. Human infections are endemic in southern China. What is the appropriate identification?


a. Fasciola hepatica
b. Fasciolopsis buski
c. Paragonimus westermani
d. Cloncorchis sinensis
Cloncorchis sinensis
(Cloncorchis sinensis is correct as the key identification is the small size of this fluke. Cloncorchis is found in China, Japan, Korea, Taiwan and Vietnam and is also known as the “Chinese liver fluke”. Light infections can be asymptomatic and heavier infections may present with fever, jaundice and abdominal pain)